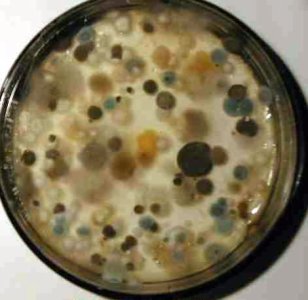
moldculturephoto010djf.jpg

^
Im quite disappointed when she (gullibly) brainwashed to credit god for her oddity

. I think that entity has no credit to put her in miserable position like.. that she must endure more hardship and struggle because of her looks.
Im glad she's confident, but the source of her confident if she only knew..is because of the legality of her case.
When I dissect that particular issue; being bearded in both sex; I notice these people created outcome differently.
A). A Natural born men doing drag-queen while keeping his beard. vs.
B). A Natural born women with genetic mishap; having a beard.
the same as:
Natural born women doing drag-king while keeping her boobs
Natural born men whose born with big titties (beyond man boobs)
https://www.youtube.com/watch?v=PmpzRN756KU#t=370
the transexual women would consider them very lucky arent they?

'Quite the opposite issues but they are having solution pointing across for acceptance.
One craving acceptance for being "inherently" deviant
The other craving acceptance for genetically deviant.
IMO. Straight Society- the holder of big legacy of how gender supposed to appear/behave (hetero-normative society); have different policy on them// they are treated by different policy.
For those born natural with opposite sex traits. I think the S.S shouldn't discriminate/bully them since these guys are in your team too. Yes they look like your odd son/daughter/ your ugly duckling but do they CHOOSE to be like that? They're naturally women/ men who fit with their role function. So they own S.S..for acceptance and if that process difficult, that becoming S.S obligation/challenge to accept them, not theirs..
so that bearded lady could wear her shades, turban and skirt while keeping her beard.
"Fuck yall bitchess, Im born this way..this is who I am" 
For those born natural but wanting to be the opposite sex. Transgender to transexual for sample or those playing gender identity mixup
Their rights from S.S is to accept them as functional human being. So they have same rights in their job, as employee, client or customer, athlete, etc.
To deny their involvement will be a violation of basic human rights.
But they dont have rights to make S.S fully accept them/ like them..Im talking about public shunning.
some people dont care about it, some people dont comfortable.. so deal with it.
I kudos Cochita for turning head and make bearded drag queen sort of like chic fad. IMO, she has a disgusting look...ugh.

Really fugly!!

..And it's a shame for a very good looking human to choose that look. I think she's trolling herself..to appear like that, sort of gimmick to make her win the contest (Euro-vision), not a honest move. Idk
it's obvious I stand for hetero-normative society and for those uncomfortable with androgynous look ( like Im included) I want to clear something:
* Some of us having disdain because of right wing influence aka religion. Im OUT from that category..100%
"because God told us to not becoming shemales or else you got stoned" God say this, god say that..what YOU actually feel for the situation?!
Right wing also tend to "demonize" them and strip androginous people from their human rights- which I strongly disagree.
IMO..Why I dislike androgynity..because my sense fucked up looking at them. X_X
If I didn't perceive them as hot..then I perceive them as beautiful. If none of above..then I usually dislike the look.
I.e= really flaming guy with purse, makeup and high heels like Johnny Weird
hate him to death...
personality like shit too. -_-
but.. 'still I let my sense to be open minded/ wandering..that's why when I watch that v.clip of drag fashion show with a bunch of flaming guys..I think "Oh, that look could be high fashion"/ editorial photo shoot/ artistic!"..then they get + point.
But again..it's not like they appear high fashion 24/7, usually flaming guys wear random put on, a mismatch of girl accessories which totally can't be wear for unisex- such as obviously girly accessories and they look fucked up/ horrible with that. Ok..some of them become overly dandy with men's clothing...straight from GQ eventhough you know they're really flaming inside..I rather have them infront of me sitting in my bus, thank you- for not giving me eyesore -_-
And dont you guys notice when an overly flaming guy usually match their frame? Emaciated? Androgynous? Hairless? Once they wax their eyebrows; Im done with them -_-
Have I seen masculine looking guy wearing flamboyant clothing?=Never. Maybe they giving me a different reaction, a new sensation ^^
Oh Sagat:
hmm hot

Pavel Patel..
he has naturally bangable body but eh...
not on that one^ fugly

How about drag queen?
I didn't dislike Drag Queen. Because Drag Queen appear fully on their opposite gender..therefore they look like woman and they're appear very nicely..
A drag show is like watching a bunch of peacock displaying their feathers..
bravo! Beautiful!

A drag queen with beard however..fucked my brain again. Therefore I dislike them.
A drag King with nice bulge?
so fuckedup-

dislike....

. I think that entity has no credit to put her in miserable position like.. that she must endure more hardship and struggle because of her looks.
. I think that entity has no credit to put her in miserable position like.. that she must endure more hardship and struggle because of her looks.








